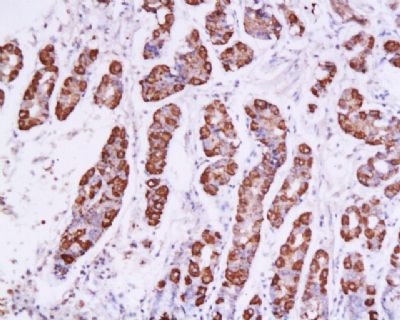
SOX2胚胎干细胞关键蛋白抗体

相关产品推荐更多 >
万千商家帮你免费找货
0 人在求购买到急需产品
- 详细信息
- 技术资料
- 免疫原:
KLH conjugated
- 亚型:
IgG
- 形态:
冻干粉
- 保存条件:
负20°保存
- 克隆性:
多克隆
- 标记物:
详情请来电索取说明书
- 适应物种:
详情请来电索取说明书
- 宿主:
Rabbit
- 应用范围:
WB=1:500-2000 ELISA=1:500-1000 IHC-P=1:400-800 IHC-F=1:400-800 IF=1:100-500
- 浓度:
1mg/ml
- 靶点:
详情请来电索取说明书
- 抗体英文名:
SOX2
- 抗体名:
胚胎干细胞关键蛋白抗体
- 规格:
100ul/200ul
| 规格: | 100ul | 产品价格: | ¥1380.0 |
|---|---|---|---|
| 规格: | 200ul | 产品价格: | ¥2200.0 |
英文名称SOX2
中文名称SOX2胚胎干细胞关键蛋白抗体
别 名transcriptional factor SOX2; ANOP3; cb236; Delta EF2a; lcc; MCOPS3; MGC148683; MGC2413; RGD1565646; Sex determining region Y box 2; Sex determining region Y-box 2; SOX 2; SRY (sex determining region Y) box 2; SRY box containing gene 2; SRY related HMG box 2; SRY related HMG box gene 2; SRY-box 2; ysb; SOX2_HUMAN; Transcription factor SOX-2; SOX2_HUMAN.
Specific References (6) | bs-0523R has been referenced in 6 publications.[IF=2.51] Gao, Qian, et al. "Expression pattern of embryonic stem cell markers in DFAT cells and ADSCs." Molecular biology reports 39.5 (2012): 5791-5804. Rat. PubMed:22237862 [IF=2.15] Liu, Yu-Hong, et al. "A signature for induced pluripotent stem cell?Cassociated genes in colorectal cancer."Medical Oncology 30.1 (2013): 1-11.( WB ; Human. PubMed:23307247 [IF=2.47] Yan, Yu-hui, et al. "Osthole Protects Bone Marrow-Derived Neural Stem Cells from Oxidative Damage through PI3K/Akt-1 Pathway." Neurochemical Research (2016): 1-8. other ; Mouse. PubMed:27734182 [IF=3.18] Liu, Yi‐Zhen, et al. "A panel of protein markers for the early detection of lung cancer with bronchial brushing specimens." Cancer cytopathology 122.11 (2014): 833-841. IHC-P ; Human. PubMed:25045014 [IF=5.23] Ma, Fanglin, et al. "Lin28a promotes self-renewal and proliferation of dairy goat spermatogonial stem cells (SSCs) through regulation of mTOR and PI3K/AKT." Scientific Reports 6 (2016): 38805. IF(ICC) ; Goat. PubMed:27941834 [IF=3.61] Wang, Li, et al. "Silencing stem cell factor attenuates stemness and inhibits migration of cancer stem cells derived from Lewis lung carcinoma cells."Tumor Biology (2015): 1-15. WB ; Mouse. PubMed:26666817
规格价格50ul 100ul 200ul
研究领域肿瘤 细胞生物 神经生物学 干细胞 细胞类型标志物
抗体来源Rabbit
克隆类型Polyclonal
交叉反应 Human, Mouse, Rat, Chicken, Dog, Pig, Cow, Horse, Rabbit, Sheep, Guinea Pig,
产品应用ELISA=1:500-1000 IHC-P=1:400-800 IHC-F=1:400-800 Flow-Cyt=1μg/Test ICC=1:100-500 IF=1:100-500 (石蜡切片需做抗原修复)
not yet tested in other applications.
optimal dilutions/concentrations should be determined by the end user.
分 子 量32kDa
细胞定位细胞核 细胞浆
性 状Lyophilized or Liquid
浓 度1mg/ml
免 疫 原KLH conjugated synthetic peptide derived from human Transcription factor SOX-2:227-317/317
亚 型IgG
纯化方法affinity purified by Protein A
储 存 液0.01M TBS(pH7.4) with 1% BSA, 0.03% Proclin300 and 50% Glycerol.
保存条件Store at -20 °C for one year. Avoid repeated freeze/thaw cycles. The lyophilized antibody is stable at room temperature for at least one month and for greater than a year when kept at -20°C. When reconstituted in sterile pH 7.4 0.01M PBS or diluent of antibody the antibody is stable for at least two weeks at 2-4 °C.
PubMedPubMed
SOX2胚胎干细胞关键蛋白抗体产品介绍background:
This intronless gene encodes a member of the SRY-related HMG-box (SOX) family of transcription factors involved in the regulation of embryonic development and in the determination of cell fate. The product of this gene is required for stem-cell maintenance in the central nervous system, and also regulates gene expression in the stomach. Mutations in this gene have been associated with optic nerve hypoplasia and with syndromic microphthalmia, a severe form of structural eye malformation. This gene lies within an intron of another gene called SOX2 overlapping transcript (SOX2OT). [provided by RefSeq, Jul 2008].
Function:
Transcription factor that forms a trimeric complex with OCT4 on DNA and controls the expression of a number of genes involved in embryonic development such as YES1, FGF4, UTF1 and ZFP206 (By similarity). Critical for early embryogenesis and for embryonic stem cell pluripotency. May function as a switch in neuronal development. Downstream SRRT target that mediates the promotion of neural stem cell self-renewal (By similarity). Keeps neural cells undifferentiated by counteracting the activity of proneural proteins and suppresses neuronal differentiation.
Subunit:
Interacts with ZSCAN10. Interacts with SOX3 and FGFR1.
Subcellular Location:
Nucleus.
Post-translational modifications:
Sumoylation inhibits binding on DNA and negatively regulates the FGF4 transactivation.
DISEASE:
Defects in SOX2 are the cause of microphthalmia syndromic type 3 (MCOPS3) [MIM:206900]. Microphthalmia is a clinically heterogeneous disorder of eye formation, ranging from small size of a single eye to complete bilateral absence of ocular tissues (anophthalmia). In many cases, microphthalmia/anophthalmia occurs in association with syndromes that include non-ocular abnormalities. MCOPS3 is characterized by the rare association of malformations including uni- or bilateral anophthalmia or microphthalmia, and esophageal atresia with trachoesophageal fistula.
Similarity:
Contains 1 HMG box DNA-binding domain.
SWISS:
P48432
Gene ID:
6657
Database links:
Entrez Gene: 6657 Human
Entrez Gene: 20674 Mouse
Omim: 184429 Human
SwissProt: P48431 Human
SwissProt: P48432 Mouse
Unigene: 518438 Human
Unigene: 65396 Mouse
Important Note:
This product as supplied is intended for research use only, not for use in human, therapeutic or diagnostic applications.
Embryonic Stem Cell Marker (胚胎干细胞标志物)
转录因子:胚胎干细胞相关蛋白Sox2是sox基因家族的一个成员,Sox2与Oct4、Nanog一样是胚胎干细胞重要的转录因子,是维持干细胞特性中起到重要的作用因子;由于它在早期胚胎发生、神经分化和晶状体发育等多种重要的发育事件中都起着关键的作用,从而引起了越来越广泛的关注。
中文名称SOX2胚胎干细胞关键蛋白抗体
别 名transcriptional factor SOX2; ANOP3; cb236; Delta EF2a; lcc; MCOPS3; MGC148683; MGC2413; RGD1565646; Sex determining region Y box 2; Sex determining region Y-box 2; SOX 2; SRY (sex determining region Y) box 2; SRY box containing gene 2; SRY related HMG box 2; SRY related HMG box gene 2; SRY-box 2; ysb; SOX2_HUMAN; Transcription factor SOX-2; SOX2_HUMAN.
Specific References (6) | bs-0523R has been referenced in 6 publications.[IF=2.51] Gao, Qian, et al. "Expression pattern of embryonic stem cell markers in DFAT cells and ADSCs." Molecular biology reports 39.5 (2012): 5791-5804. Rat. PubMed:22237862 [IF=2.15] Liu, Yu-Hong, et al. "A signature for induced pluripotent stem cell?Cassociated genes in colorectal cancer."Medical Oncology 30.1 (2013): 1-11.( WB ; Human. PubMed:23307247 [IF=2.47] Yan, Yu-hui, et al. "Osthole Protects Bone Marrow-Derived Neural Stem Cells from Oxidative Damage through PI3K/Akt-1 Pathway." Neurochemical Research (2016): 1-8. other ; Mouse. PubMed:27734182 [IF=3.18] Liu, Yi‐Zhen, et al. "A panel of protein markers for the early detection of lung cancer with bronchial brushing specimens." Cancer cytopathology 122.11 (2014): 833-841. IHC-P ; Human. PubMed:25045014 [IF=5.23] Ma, Fanglin, et al. "Lin28a promotes self-renewal and proliferation of dairy goat spermatogonial stem cells (SSCs) through regulation of mTOR and PI3K/AKT." Scientific Reports 6 (2016): 38805. IF(ICC) ; Goat. PubMed:27941834 [IF=3.61] Wang, Li, et al. "Silencing stem cell factor attenuates stemness and inhibits migration of cancer stem cells derived from Lewis lung carcinoma cells."Tumor Biology (2015): 1-15. WB ; Mouse. PubMed:26666817
规格价格50ul 100ul 200ul
研究领域肿瘤 细胞生物 神经生物学 干细胞 细胞类型标志物
抗体来源Rabbit
克隆类型Polyclonal
交叉反应 Human, Mouse, Rat, Chicken, Dog, Pig, Cow, Horse, Rabbit, Sheep, Guinea Pig,
产品应用ELISA=1:500-1000 IHC-P=1:400-800 IHC-F=1:400-800 Flow-Cyt=1μg/Test ICC=1:100-500 IF=1:100-500 (石蜡切片需做抗原修复)
not yet tested in other applications.
optimal dilutions/concentrations should be determined by the end user.
分 子 量32kDa
细胞定位细胞核 细胞浆
性 状Lyophilized or Liquid
浓 度1mg/ml
免 疫 原KLH conjugated synthetic peptide derived from human Transcription factor SOX-2:227-317/317
亚 型IgG
纯化方法affinity purified by Protein A
储 存 液0.01M TBS(pH7.4) with 1% BSA, 0.03% Proclin300 and 50% Glycerol.
保存条件Store at -20 °C for one year. Avoid repeated freeze/thaw cycles. The lyophilized antibody is stable at room temperature for at least one month and for greater than a year when kept at -20°C. When reconstituted in sterile pH 7.4 0.01M PBS or diluent of antibody the antibody is stable for at least two weeks at 2-4 °C.
PubMedPubMed
SOX2胚胎干细胞关键蛋白抗体产品介绍background:
This intronless gene encodes a member of the SRY-related HMG-box (SOX) family of transcription factors involved in the regulation of embryonic development and in the determination of cell fate. The product of this gene is required for stem-cell maintenance in the central nervous system, and also regulates gene expression in the stomach. Mutations in this gene have been associated with optic nerve hypoplasia and with syndromic microphthalmia, a severe form of structural eye malformation. This gene lies within an intron of another gene called SOX2 overlapping transcript (SOX2OT). [provided by RefSeq, Jul 2008].
Function:
Transcription factor that forms a trimeric complex with OCT4 on DNA and controls the expression of a number of genes involved in embryonic development such as YES1, FGF4, UTF1 and ZFP206 (By similarity). Critical for early embryogenesis and for embryonic stem cell pluripotency. May function as a switch in neuronal development. Downstream SRRT target that mediates the promotion of neural stem cell self-renewal (By similarity). Keeps neural cells undifferentiated by counteracting the activity of proneural proteins and suppresses neuronal differentiation.
Subunit:
Interacts with ZSCAN10. Interacts with SOX3 and FGFR1.
Subcellular Location:
Nucleus.
Post-translational modifications:
Sumoylation inhibits binding on DNA and negatively regulates the FGF4 transactivation.
DISEASE:
Defects in SOX2 are the cause of microphthalmia syndromic type 3 (MCOPS3) [MIM:206900]. Microphthalmia is a clinically heterogeneous disorder of eye formation, ranging from small size of a single eye to complete bilateral absence of ocular tissues (anophthalmia). In many cases, microphthalmia/anophthalmia occurs in association with syndromes that include non-ocular abnormalities. MCOPS3 is characterized by the rare association of malformations including uni- or bilateral anophthalmia or microphthalmia, and esophageal atresia with trachoesophageal fistula.
Similarity:
Contains 1 HMG box DNA-binding domain.
SWISS:
P48432
Gene ID:
6657
Database links:
Entrez Gene: 6657 Human
Entrez Gene: 20674 Mouse
Omim: 184429 Human
SwissProt: P48431 Human
SwissProt: P48432 Mouse
Unigene: 518438 Human
Unigene: 65396 Mouse
Important Note:
This product as supplied is intended for research use only, not for use in human, therapeutic or diagnostic applications.
Embryonic Stem Cell Marker (胚胎干细胞标志物)
转录因子:胚胎干细胞相关蛋白Sox2是sox基因家族的一个成员,Sox2与Oct4、Nanog一样是胚胎干细胞重要的转录因子,是维持干细胞特性中起到重要的作用因子;由于它在早期胚胎发生、神经分化和晶状体发育等多种重要的发育事件中都起着关键的作用,从而引起了越来越广泛的关注。
| 产品图片 | ![]() Tissue/cell: human stomach tissue; 4% Paraformaldehyde-fixed and paraffin-embedded; Antigen retrieval: citrate buffer ( 0.01M, pH 6.0 ), Boiling bathing for 15min; Block endogenous peroxidase by 3% Hydrogen peroxide for 30min; Blocking buffer (normal goat serum,C-0005) at 37℃ for 20 min; Incubation: Anti-Sox-2 Polyclonal Antibody, Unconjugated(bs-0523R) 1:200, overnight at 4°C, followed by conjugation to the secondary antibody(SP-0023) and DAB(C-0010) staining ![]() Paraformaldehyde-fixed, paraffin embedded (Mouse embryo); Antigen retrieval by boiling in sodium citrate buffer (pH6.0) for 15min; Block endogenous peroxidase by 3% hydrogen peroxide for 20 minutes; Blocking buffer (normal goat serum) at 37°C for 30min; Antibody incubation with (SOX2) Polyclonal Antibody, Unconjugated (bs-0523R) at 1:400 overnight at 4°C, followed by operating according to SP Kit(Rabbit) (sp-0023) instructionsand DAB staining. ![]() Paraformaldehyde-fixed, paraffin embedded (Rat brain); Antigen retrieval by boiling in sodium citrate buffer (pH6.0) for 15min; Block endogenous peroxidase by 3% hydrogen peroxide for 20 minutes; Blocking buffer (normal goat serum) at 37°C for 30min; Antibody incubation with (SOX2) Polyclonal Antibody, Unconjugated (bs-0523R) at 1:400 overnight at 4°C, followed by operating according to SP Kit(Rabbit) (sp-0023) instructionsand DAB staining. ![]() Paraformaldehyde-fixed, paraffin embedded (Mouse brain); Antigen retrieval by boiling in sodium citrate buffer (pH6.0) for 15min; Block endogenous peroxidase by 3% hydrogen peroxide for 20 minutes; Blocking buffer (normal goat serum) at 37°C for 30min; Antibody incubation with (SOX2) Polyclonal Antibody, Unconjugated (bs-0523R) at 1:400 overnight at 4°C, followed by operating according to SP Kit(Rabbit) (sp-0023) instructionsand DAB staining. ![]() Cell: NCCIT Concentration:1:100 Host/Isotype:Rabbit/IgG Flow cytometric analysis of Rabbit IgG isotype control (Cat#: bs-0523R) on NCCIT(green) compared with control in the absence of primary antibody (blue) followed by Alexa Fluor 488-conjugated goat anti-rabbit IgG(H+L) secondary antibody . |
风险提示:丁香通仅作为第三方平台,为商家信息发布提供平台空间。用户咨询产品时请注意保护个人信息及财产安全,合理判断,谨慎选购商品,商家和用户对交易行为负责。对于医疗器械类产品,请先查证核实企业经营资质和医疗器械产品注册证情况。
技术资料暂无技术资料 索取技术资料
SOX2胚胎干细胞关键蛋白抗体
¥1380 - 2200